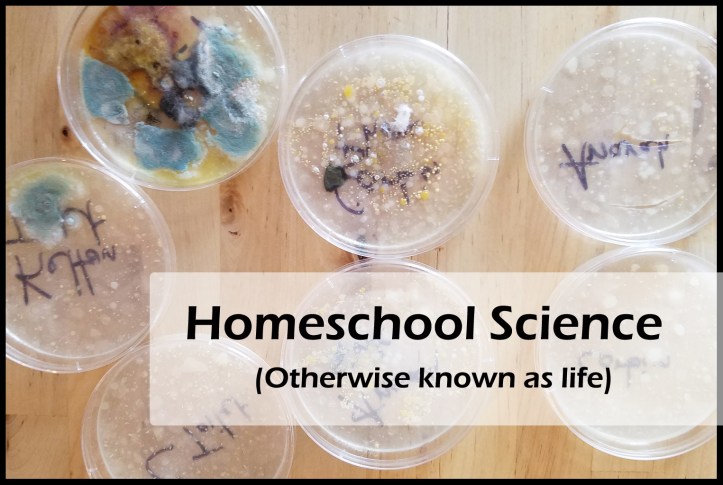
petri

She paused during writing notes and watched in fascinated disgust as I pointed out the tiny wriggling larva to the kids. After they ran off to go play again, she said “You make everything a science project, don’t you?” I paused for a second as I thought about what this therapist had already seen of our lives before I burst out laughing and said “pretty much, yup!”
She saw us discuss the life-cycle of braconid wasps (who lay eggs under the skin of hornworm caterpillars) and got to see us release the hatched wasps. She’s had to avert eye-contact from the bread slices taped to the cabinets for weeks as we bet on who was the germiest kid. She watched us check our petri dishes to see if the toilet or kitchen sink was germier. And now, she’s eyeing the gnat trap from a safe distance.
I think we’re her first real exposure to homeschooling. If not the first, probably the grossest.
It’s funny and not all that amusing at the same time. Yes, we’re homeschooling. If life happens to dump a learning opportunity in my lap, then I will seize the chance to do something with it. Especially because we’re at that gross-is-best stage for learning.
The gnat thing was probably a little overkill, but I was personally fascinated and appalled at how fast the gnats lay eggs, and how fast those eggs hatched. (A box of orchard apples had one go bad buried inside that I didn’t catch in time.) We had been battling those pesky gnats for a week and I couldn’t eliminate them. I know why now – they breed like, well…flies!
I don’t want to make everything a “learning opportunity” because that gets boring. Droning facts at the kids all the time makes them tune me out, but if I’m genuinely interested in something they tend to pay more attention. And I was genuinely interested – knowing more about the gnats helped me figure out where they were hatching. I even did a few experiments on how hardy the larva were – turns out they survive temperatures of 50 degrees fahrenheit, but not freezing. (In case you’re interested, sink drains, litter boxes, and houseplants are prime sources for hatching.)
I think she was a little taken-aback by how much our school permeates our lives. If you’re accustomed to kids sitting still and doing book work or listening to a teacher, then our lives probably look chaotic and neglectful. I’m hoping that as she sees more of how learning isn’t limited in our house that she’ll understand more how this works for us.
After all, we have the kid who built Stonehenge for fun out of Jenga blocks. The one who loves watching videos about the solar system, and ran around this week pretending he was an astronaut visiting the planets. He went by name and colors/characteristics (our floor rug with concentric circles was Saturn, and the blue exercise ball was Neptune.) The same kid who discussed selling his styrofoam sculpture to a museum because it was art.
The beauty of homeschooling is that learning isn’t limited to only certain hours of the day. If we go to a museum on a weekend, learning happens. If we discuss philosophical ideas at bedtime, that counts. If we practise counting by checking the calendar to see how many days until Christmas, it’s just part of our day. No forced learning, no spoon-fed information, and no homework. As the Engineer gets older and more textbooks come into play, I’m sure our lives will look a little more “schooly.” The freedom will still be there, just altered a bit.
Not everyone feels the same way. Not everyone can or wants to commit to homeschooling. Not every kid will do well in a less structured format. There are plenty of schools out there with teachers who love sharing the same things with their students that I do with my kids. What we’re doing isn’t unique or new at all – except to our kids. Our kids are filled with curiosity, joy, and wonder. They love learning because it’s not a chore to them.
That’s really what I want: for my kids to live and breathe learning as a way of life. Homeschooling gives them that opportunity. Even if that means observing gnat larva or the extraordinarily gross bacteria from our toilet. It’s life, our life, and we’re learning. Works for us!
You do you! That is so awesome. We start Squishy’s therapy next month and I am a little worried about the home visits and what they will think of our homeschool environment.
LikeLike
Good luck with the therapy! Our therapist might think we’re a little weird, but they can clearly see that the Engineer is learning and that we’re committed to doing what’s best for him. I think every therapist wishes that for all of “their” kids and won’t even give your homeschool environment a second thought!
LikeLike